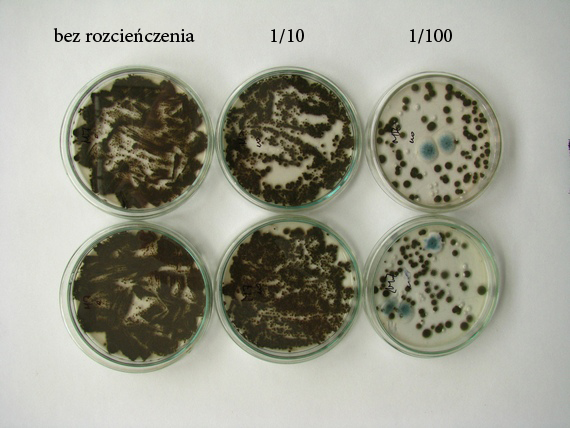
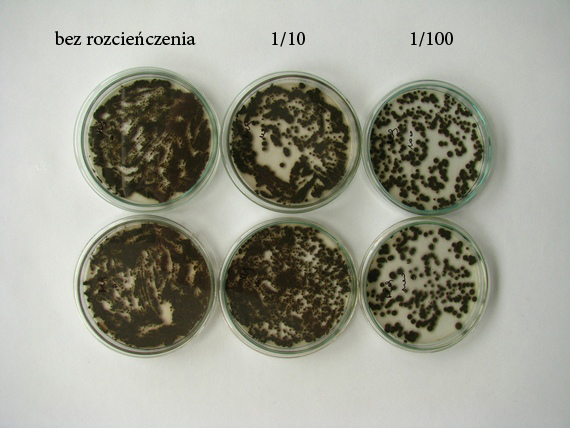
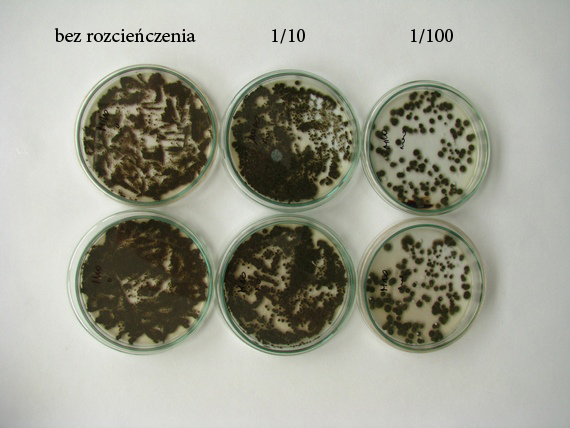

ROZCIEŃCZENIA
Założono, że próby pobierano z powierzchni około 0,25 dm2, z miejsc reprezentatywnych dla obiektu albo podejrzanych o działalność mikrobiologiczną lub wody (plamy, zacieki itp.). Wymazówkę przeniesiono do sterylnej probówki, zalano 4 ml jałowej wody destylowanej, probówkę wytrząsano na mikserze laboratoryjnym przez 30 sekund tak, aby poziom roztworu nie przekraczał odległości 2 cm od krawędzi probówki. Usunięto wymazówkę z probówki. Wykonano rozcieńczenia 1/10 i 1/100 (200μl roztworu rozcieńczanego i 1800μl jałowej wody destylowanej) Z roztworu podstawowego i rozcieńczeń po 30 sekundowym wytrząsaniu wysiano po 100μl na podłoże MEA. Po 14 dniach inkubacji w warunkach pokojowych oceniono wzrost mikroorganizmów na szalkach.

Kubo, bardzo mi się to podoba – ale dlaczego to robicie?
Czy rozcieńczenia pomagają w oznaczaniu rodzajów grzybów i ich ilości – czy potem to przeliczacie statystycznie na większe powierzchnie? może wyjaśnisz a ten komentarz możesz skasować 🙂
Próby pobierane są z powierzchni 5 cm x 5 cm natomiast wyniki przeliczane są na powierzchnię 1 m2
Przed wykonaniem posiewu nie wiemy jaka ilość jednostek tworzących kolonie (j.t.k.) znajduje się na wymazówce. Na zdjęciach widać, że zdarzają się sytuacje, w których warianty bez rozcieńczenia oraz 1/10 nie pozwalają na rozróżnienie poszczególnych kolonii. W związku z tym, że rozcieńczeń materiału wyjściowego nie da się odłożyć w czasie wykonuje się je obligatoryjnie.
Ponadto potrójne rozcieńczenie i dwukrotne powtórzenie pozwala na dodatkową weryfikację poprawności wyników i wychwycenie przypadkowych zakażeń np. z powietrza.
Oczywiście również zdarzają się przypadki, w których ilość koloni na szalce bez rozcieńczenia wynosi mniej niż 10 szt.
Czyli – mówiąc ludzkim głosem, jeśli się próbki nie rozcieńczy efekt jest „za gęsty” by móc prawidłowo ocenić co faktycznie wyrosło?
Niekiedy rozcieńczenie jest wręcz niezbędne. Daje szansę na rozwój organizmów rosnących wolniej od innych. Te, które wyrastają szybciej i są w dużej ilości potrafią zabrać wszystkie dostępne zasoby (pokarmowe) i zaburzyć wynik badania.